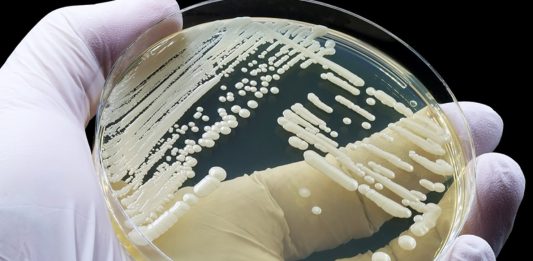
Candida auris: Ο θανατηφόρος μύκητας που εξαπλώνεται ραγδαία! Είστε μόνοι!

Είστε έτοιμοι για ένα ακόμη όμορφο concept του Surface Andromeda phone;
Ακούμε συνεχώς για μια τέτοια συσκευή εκ μέρους της Microsoft, χωρίς όμως να βλέπουμε μια τέτοια. Ωστόσο όμως, πολλοί έχουν προσπαθήσει να φέρουν στη...
Η άνοδος, η πτώση και η αναγέννηση των slider smartphones
Το τελευταίο χρονικό διάστημα, παρατηρούμε όλοι την αναβίωση των Slider smartphones, καθώς ικανοποιούν μια νέα πρακτική ανάγκη. Στις πρώτες ημέρες, αποσκοπούσαν να κάνουν ένα...
To Xiaomi Mi Max 3 λαμβάνει το Android 9 Pie
Έφθασε το Android 9 Pie και στο Xiaomi Mi Max 3, όπως χαρακτηριστικά διαβάζουμε σε ανάρτηση της σελίδας του Facebook, Greek Xiaomi Lovers.
Όπως βλέπουμε...
Οι διαθέσιμες εκδόσεις αποθηκευτικού χώρου όλης της σειράς Galaxy S10
Ύστερα από ολόκληρους μήνες φημών, γνωρίζουμε τελικά τις διαθέσιμες εκδόσεις αποθηκευτικού χώρου ολόκληρης της σειράς Galaxy S10. Όσον αφορά το φθηνότερο μοντέλο, το Galaxy...
Αυτό το feature του Play Store σου δείχνει πόσο χώρο έχει η συσκευή σου ακόμη
Όταν ένας χρήστης του Android ανοίγει το Google Play Store και ελέγχει εφαρμογές που έχει ήδη εγκαταστήσει, μια νέα ένδειξη θα εμφανίζεται, για το...
Το πιο γρήγορο Wi-Fi είναι επιτέλους εδώ!
Το Wi-Fi εισέρχεται σε μια διαδικασία αναβάθμισης, από εκείνες που συμβαίνουν μόνο μια φορά στα πέντε χρόνια. Αλλά αν και αυτή, η πιο γρήγορη...
Xiaomi Redmi Note 7: Μπορεί να μην έχει πιστοποίηση IP, είναι όμως αδιάβροχο (στο περίπου)
Το Redmi Note 7 έκανε το επίσημο ντεμπούτο του μόλις πριν από δυο ημέρες, αλλά η επίσημη ανακοίνωση της εταιρείας παρέλειψε να αναφέρει ένα...
Αυτό είναι ένα prototype του OnePlus 7!
Μια νέα φωτογραφία δημοσιεύεται σήμερα η οποία δείχνει την μπροστινή πλευρά του OnePlus 7 smartphone που ετοιμάζει η OnePlus. Όσον αφορά το πάνω bezel,...
Μπορούμε τελικά να διαπιστώσουμε ποια smartphones έχουν την καλύτερη λήψη σήματος πριν την αγορά;
Η εφημερίδα The Guardian λαμβάνει συχνά ερωτήματα αναγνωστών και δίνει απαντήσεις μέσω άρθρων που δημοσιεύει. Ένα τέτοιο ερώτημα έλαβε πριν από μερικές ημέρες η...
Το Pro mode video recording απουσιάζει στα Galaxy S9 και Galaxy Note 9 (Android Pie)
Σε μια προσπάθεια να δώσει τα Galaxy S9 και Galaxy Note 9 Android Pie updates όσο πιο σύντομα μπορούσε, η Samsung έχει ξεχάσει...